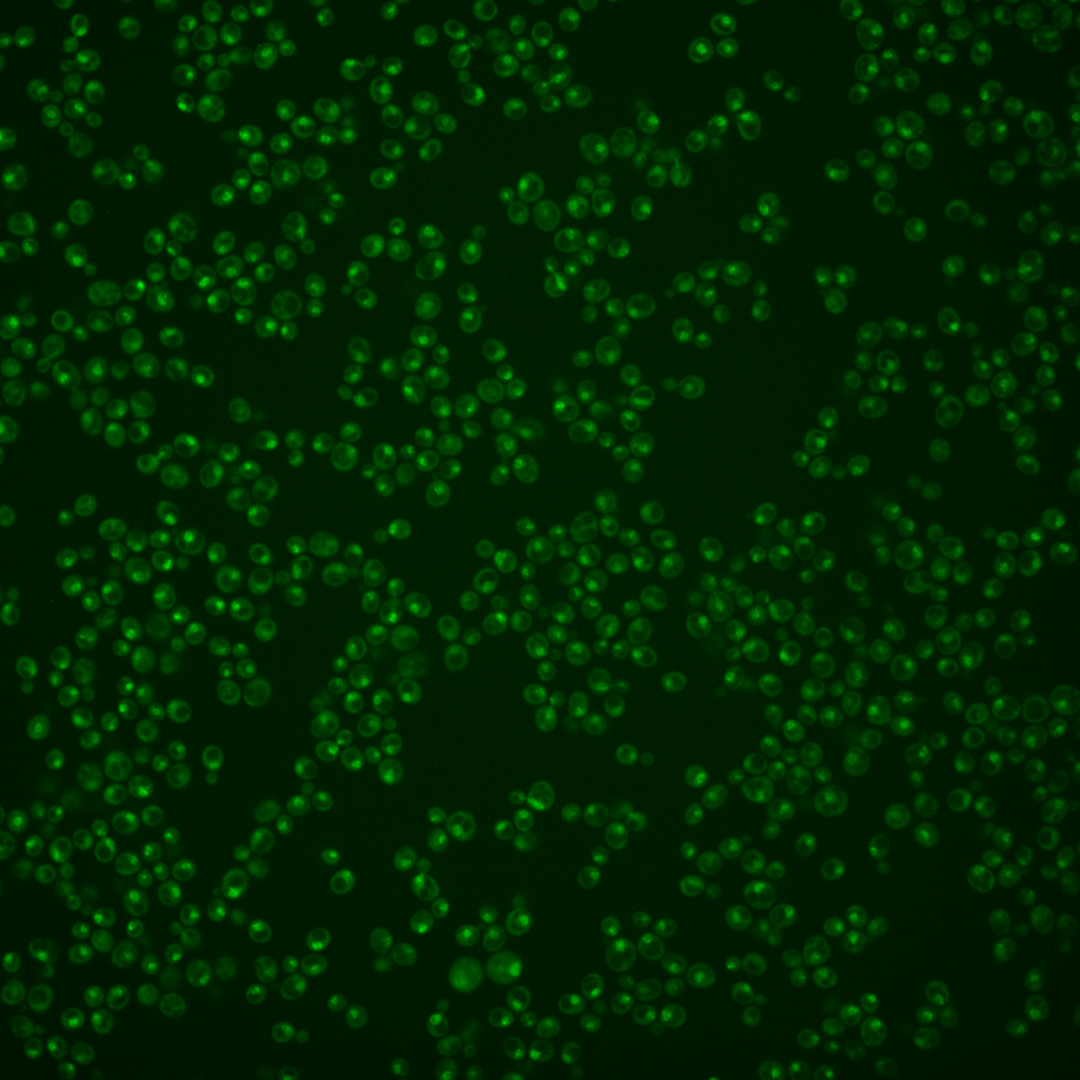
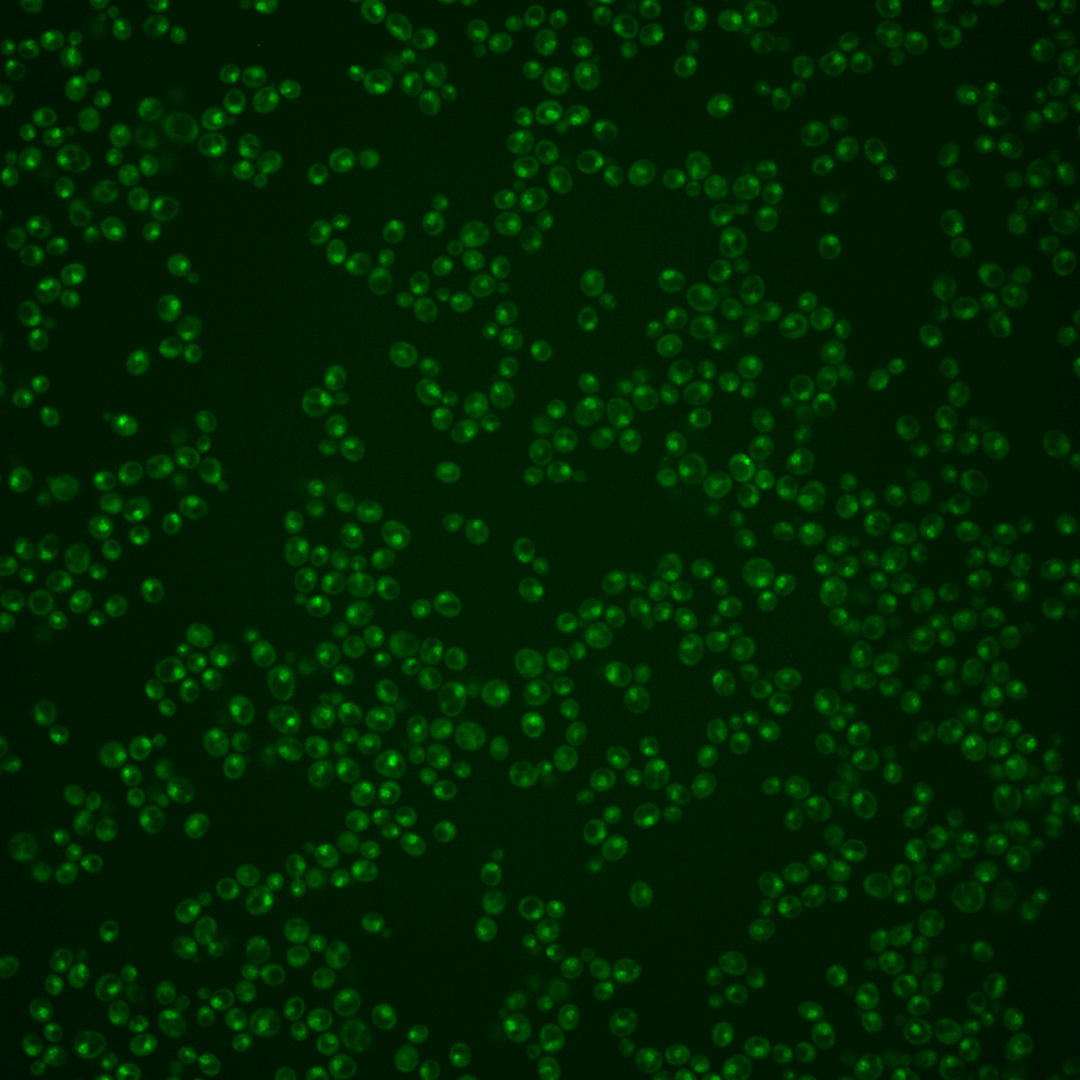
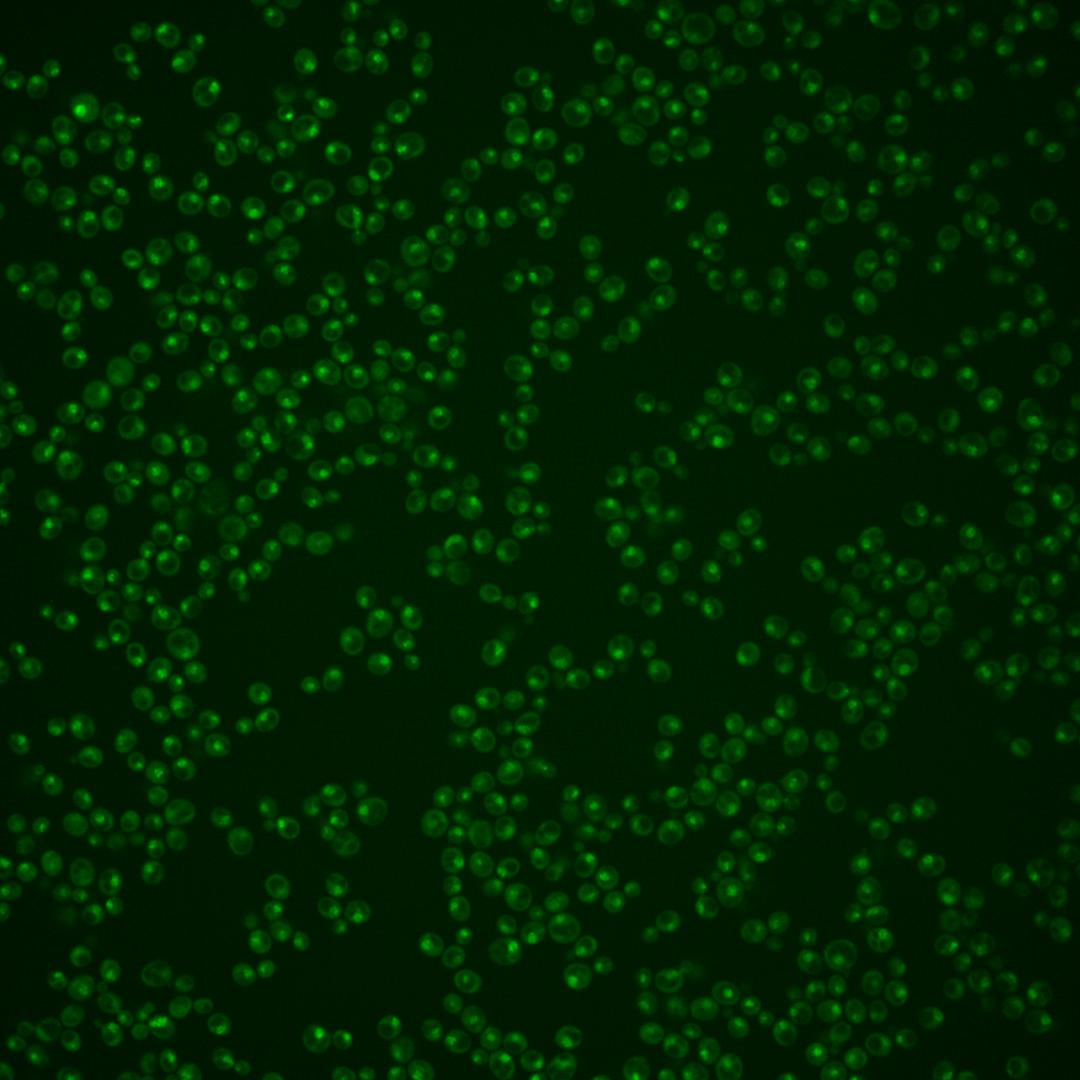

| Standard name | |
|---|---|
| Human Ortholog | |
| Description | Protein that localizes to chromatin; has a role in regulation of histone gene expression; has a bromodomain-like region that interacts with the N-terminal tail of histone H3, and an ATPase domain; relocalizes to the cytosol in response to hypoxia; potentially phosphorylated by Cdc28p |
Micrographs




















































































Sub-cellular Localization
Yeast GFP Assignment
Protein Abundance
Localization Change
External localization resources
| ensLOC | DeepLoc | |||||||||||||||||||||||
|---|---|---|---|---|---|---|---|---|---|---|---|---|---|---|---|---|---|---|---|---|---|---|---|---|
| Localization | WT1 | WT2 | WT3 | RAP60 | RAP140 | RAP220 | RAP300 | RAP380 | RAP460 | RAP540 | RAP620 | RAP700 | HU80 | HU120 | HU160 | rpd3Δ_1 | rpd3Δ_2 | rpd3Δ_3 | WT1 | WT2 | WT3 | AF100 | AF140 | AF180 |
| Cortical Patches | 0 | 0 | 0 | 0 | 0 | 0 | 0 | 1 | 0 | 0 | 0 | 0 | 0 | 0 | 2 | 0 | 0 | 0 | 0 | 0 | 0 | 1 | 5 | 1 |
| Bud | 0 | 2 | 2 | 0 | 0 | 0 | 2 | 4 | 6 | 1 | 9 | 2 | 0 | 0 | 1 | 0 | 0 | 0 | 3 | 2 | 2 | 2 | 2 | 1 |
| Bud Neck | 0 | 0 | 0 | 0 | 0 | 0 | 1 | 1 | 0 | 0 | 1 | 0 | 0 | 0 | 0 | 0 | 0 | 0 | 0 | 0 | 1 | 0 | 3 | 2 |
| Bud Site | 0 | 0 | 1 | 4 | 3 | 12 | 10 | 7 | 15 | 16 | 7 | 23 | 0 | 1 | 5 | 0 | 0 | 0 | – | – | – | – | – | – |
| Cell Periphery | 0 | 1 | 0 | 0 | 0 | 0 | 1 | 0 | 0 | 0 | 0 | 0 | 0 | 0 | 0 | 0 | 0 | 0 | 0 | 0 | 0 | 0 | 0 | 0 |
| Cytoplasm | 9 | 6 | 10 | 7 | 21 | 15 | 20 | 22 | 14 | 14 | 5 | 3 | 40 | 69 | 65 | 14 | 21 | 16 | 1 | 2 | 0 | 2 | 0 | 1 |
| Endoplasmic Reticulum | 1 | 1 | 3 | 1 | 1 | 1 | 1 | 1 | 0 | 0 | 0 | 0 | 0 | 0 | 2 | 2 | 2 | 4 | 0 | 0 | 0 | 2 | 1 | 1 |
| Endosome | 0 | 2 | 0 | 0 | 3 | 0 | 3 | 1 | 0 | 0 | 0 | 0 | 4 | 5 | 2 | 2 | 2 | 6 | 5 | 5 | 5 | 1 | 9 | 12 |
| Golgi | 2 | 0 | 0 | 0 | 0 | 0 | 0 | 0 | 0 | 0 | 0 | 0 | 0 | 0 | 2 | 2 | 0 | 0 | 2 | 2 | 3 | 1 | 5 | 6 |
| Mitochondria | 1 | 75 | 118 | 111 | 63 | 219 | 233 | 233 | 287 | 257 | 187 | 223 | 4 | 5 | 24 | 1 | 3 | 16 | 3 | 4 | 3 | 1 | 5 | 9 |
| Nucleus | 276 | 415 | 375 | 252 | 277 | 382 | 441 | 442 | 335 | 295 | 204 | 263 | 307 | 396 | 412 | 74 | 85 | 111 | 236 | 418 | 325 | 199 | 308 | 300 |
| Nuclear Periphery | 3 | 8 | 3 | 2 | 5 | 5 | 12 | 10 | 8 | 16 | 10 | 7 | 6 | 4 | 8 | 1 | 1 | 0 | 2 | 1 | 1 | 2 | 1 | 1 |
| Nucleolus | 62 | 44 | 41 | 30 | 34 | 56 | 99 | 92 | 96 | 108 | 78 | 111 | 35 | 41 | 47 | 1 | 4 | 10 | 90 | 56 | 70 | 36 | 112 | 116 |
| Peroxisomes | 0 | 0 | 0 | 0 | 0 | 0 | 0 | 0 | 0 | 0 | 0 | 0 | 3 | 8 | 7 | 1 | 0 | 0 | 0 | 0 | 0 | 0 | 0 | 0 |
| SpindlePole | 9 | 3 | 13 | 0 | 6 | 6 | 4 | 7 | 0 | 3 | 2 | 4 | 3 | 7 | 14 | 3 | 2 | 4 | 8 | 6 | 8 | 3 | 7 | 12 |
| Vac/Vac Membrane | 6 | 7 | 2 | 1 | 4 | 1 | 2 | 3 | 0 | 3 | 0 | 0 | 5 | 2 | 6 | 4 | 8 | 7 | 14 | 22 | 25 | 16 | 34 | 41 |
| Unique Cell Count | 328 | 478 | 439 | 292 | 344 | 481 | 607 | 592 | 480 | 445 | 306 | 394 | 365 | 500 | 530 | 97 | 121 | 146 | 371 | 525 | 455 | 278 | 505 | 513 |
| Labelled Cell Count | 369 | 564 | 568 | 408 | 417 | 697 | 829 | 824 | 761 | 713 | 503 | 636 | 407 | 538 | 597 | 105 | 128 | 174 | 371 | 525 | 455 | 278 | 505 | 513 |
Yeast GFP Assignment
Protein Abundance
| Screen | WT1 | WT2 | WT3 | RAP60 | RAP140 | RAP220 | RAP300 | RAP380 | RAP460 | RAP540 | RAP620 | RAP700 | HU80 | HU120 | HU160 | rpd3Δ_1 | rpd3Δ_2 | rpd3Δ_3 | AF100 | AF140 | AF180 |
|---|---|---|---|---|---|---|---|---|---|---|---|---|---|---|---|---|---|---|---|---|---|
| Mean Cell GFP Intensity (1e-4) | 7.8 | 5.6 | 4.7 | 4.6 | 5.0 | 4.2 | 4.3 | 4.4 | 3.9 | 3.9 | 3.8 | 3.9 | 6.8 | 6.5 | 5.8 | 8.2 | 9.2 | 8.0 | 6.9 | 6.9 | 7.4 |
| Std Deviation (1e-4) | 1.2 | 1.0 | 0.8 | 1.1 | 1.5 | 1.1 | 1.4 | 1.3 | 1.1 | 1.4 | 0.9 | 1.0 | 1.6 | 1.7 | 1.5 | 2.2 | 2.7 | 2.4 | 1.9 | 1.5 | 1.6 |
| Intensity Change (Log2) | – | – | – | -0.02 | 0.11 | -0.13 | -0.13 | -0.07 | -0.26 | -0.25 | -0.29 | -0.27 | 0.54 | 0.49 | 0.32 | 0.82 | 0.98 | 0.78 | 0.57 | 0.57 | 0.67 |
Localization Change
| Localization | RAP60 | RAP140 | RAP220 | RAP300 | RAP380 | RAP460 | RAP540 | RAP620 | RAP700 | HU80 | HU120 | HU160 | rpd3Δ_1 | rpd3Δ_2 | rpd3Δ_3 |
|---|---|---|---|---|---|---|---|---|---|---|---|---|---|---|---|
| Cortical Patches | 0 | 0 | 0 | 0 | 0 | 0 | 0 | 0 | 0 | 0 | 0 | 0 | 0 | 0 | 0 |
| Bud | 0 | 0 | 0 | 0 | 0 | 0 | 0 | 0 | 0 | 0 | 0 | 0 | 0 | 0 | 0 |
| Bud Neck | 0 | 0 | 0 | 0 | 0 | 0 | 0 | 0 | 0 | 0 | 0 | 0 | 0 | 0 | 0 |
| Bud Site | 0 | 0 | 0 | 0 | 0 | 0 | 0 | 0 | 0 | 0 | 0 | 0 | 0 | 0 | 0 |
| Cell Periphery | 0 | 0 | 0 | 0 | 0 | 0 | 0 | 0 | 0 | 0 | 0 | 0 | 0 | 0 | 0 |
| Cytoplasm | 0.1 | 2.7 | 0.8 | 1.0 | 1.3 | 0.6 | 0.8 | -0.6 | -1.8 | 5.1 | 6.3 | 5.8 | 0 | 6.4 | 4.4 |
| Endoplasmic Reticulum | 0 | 0 | 0 | 0 | 0 | 0 | 0 | 0 | 0 | 0 | 0 | 0 | 0 | 0 | 0 |
| Endosome | 0 | 0 | 0 | 0 | 0 | 0 | 0 | 0 | 0 | 0 | 0 | 0 | 0 | 0 | 0 |
| Golgi | 0 | 0 | 0 | 0 | 0 | 0 | 0 | 0 | 0 | 0 | 0 | 0 | 0 | 0 | 0 |
| Mitochondria | 0 | -2.8 | 0 | 0 | 0 | 0 | 0 | 0 | 0 | -10.1 | -11.7 | -9.8 | -5.5 | -5.8 | -4.0 |
| Nucleus | 0.3 | -1.8 | -2.4 | -4.9 | -4.2 | -5.6 | -6.6 | -6.1 | -6.4 | -0.5 | -2.5 | -3.0 | -2.2 | -3.9 | -2.6 |
| Nuclear Periphery | 0 | 0 | 0 | 0 | 0 | 0 | 0 | 0 | 0 | 0 | 0 | 0 | 0 | 0 | 0 |
| Nucleolus | 0 | 0.3 | 0 | 0 | 0 | 0 | 0 | 0 | 0 | 0.1 | -0.6 | -0.3 | -2.8 | -2.2 | -0.9 |
| Peroxisomes | 0 | 0 | 0 | 0 | 0 | 0 | 0 | 0 | 0 | 0 | 0 | 0 | 0 | 0 | 0 |
| SpindlePole | 0 | -1.1 | 0 | 0 | 0 | 0 | 0 | 0 | 0 | -2.2 | -1.7 | -0.3 | 0 | 0 | 0 |
| Vacuole | 0 | 0 | 0 | 0 | 0 | 0 | 0 | 0 | 0 | 0 | 0 | 0 | 0 | 0 | 0 |
External localization resources
Images






























Protein Concentration and Protein Localization Data
| R1 | R2 | R3 | ||||||||||||||||
|---|---|---|---|---|---|---|---|---|---|---|---|---|---|---|---|---|---|---|
| G1 Pre-START | G1 Post-START | S/G2 | Metaphase | Anaphase | Telophase | G1 Pre-START | G1 Post-START | S/G2 | Metaphase | Anaphase | Telophase | G1 Pre-START | G1 Post-START | S/G2 | Metaphase | Anaphase | Telophase | |
| Concentration | – | – | – | – | – | – | – | – | – | – | – | – | – | – | – | – | – | – |
| Actin | 0 | 0 | 0 | 0 | 0.0001 | 0 | – | – | – | – | – | – | 0.0064 | 0 | 0.0009 | 0 | 0 | 0 |
| Bud | 0 | 0 | 0 | 0 | 0 | 0 | – | – | – | – | – | – | 0 | 0 | 0 | 0 | 0 | 0 |
| Bud Neck | 0.0001 | 0.0001 | 0.0001 | 0 | 0.0015 | 0.0008 | – | – | – | – | – | – | 0.0004 | 0.0001 | 0 | 0.0001 | 0.0006 | 0.0005 |
| Bud Periphery | 0 | 0 | 0 | 0 | 0.0001 | 0 | – | – | – | – | – | – | 0.0001 | 0 | 0 | 0 | 0.0001 | 0.0001 |
| Bud Site | 0 | 0 | 0 | 0 | 0.0001 | 0 | – | – | – | – | – | – | 0.0003 | 0 | 0 | 0 | 0.0001 | 0.0001 |
| Cell Periphery | 0 | 0 | 0 | 0 | 0 | 0 | – | – | – | – | – | – | 0 | 0 | 0 | 0 | 0 | 0 |
| Cytoplasm | 0.0001 | 0 | 0 | 0 | 0 | 0 | – | – | – | – | – | – | 0.0001 | 0 | 0 | 0 | 0.0001 | 0 |
| Cytoplasmic Foci | 0 | 0 | 0 | 0 | 0 | 0 | – | – | – | – | – | – | 0.0003 | 0 | 0.0002 | 0 | 0 | 0 |
| Eisosomes | 0 | 0 | 0 | 0 | 0 | 0 | – | – | – | – | – | – | 0.0002 | 0 | 0 | 0 | 0 | 0 |
| Endoplasmic Reticulum | 0 | 0 | 0 | 0 | 0 | 0 | – | – | – | – | – | – | 0.0002 | 0 | 0 | 0 | 0 | 0 |
| Endosome | 0 | 0 | 0 | 0 | 0.0001 | 0 | – | – | – | – | – | – | 0.0005 | 0 | 0 | 0 | 0 | 0 |
| Golgi | 0 | 0 | 0 | 0 | 0 | 0 | – | – | – | – | – | – | 0.0004 | 0 | 0.0001 | 0 | 0 | 0 |
| Lipid Particles | 0 | 0 | 0.0001 | 0 | 0.0001 | 0 | – | – | – | – | – | – | 0.001 | 0 | 0.0007 | 0 | 0 | 0 |
| Mitochondria | 0.0004 | 0 | 0.0001 | 0 | 0.0003 | 0 | – | – | – | – | – | – | 0.0003 | 0.0001 | 0.0003 | 0.0001 | 0.0002 | 0.0002 |
| None | 0 | 0 | 0 | 0 | 0.0001 | 0 | – | – | – | – | – | – | 0.0004 | 0 | 0 | 0 | 0.0001 | 0 |
| Nuclear Periphery | 0.0004 | 0.0021 | 0.0013 | 0.0005 | 0.0012 | 0.0004 | – | – | – | – | – | – | 0.0012 | 0.0009 | 0.0035 | 0.0009 | 0.0018 | 0.0004 |
| Nucleolus | 0.0592 | 0.0455 | 0.0366 | 0.0234 | 0.1681 | 0.132 | – | – | – | – | – | – | 0.0514 | 0.05 | 0.0358 | 0.0301 | 0.2352 | 0.0969 |
| Nucleus | 0.9376 | 0.9478 | 0.9591 | 0.9747 | 0.8221 | 0.8634 | – | – | – | – | – | – | 0.9344 | 0.9426 | 0.9474 | 0.9678 | 0.7197 | 0.8931 |
| Peroxisomes | 0 | 0 | 0 | 0 | 0 | 0 | – | – | – | – | – | – | 0.0003 | 0 | 0.0069 | 0 | 0 | 0 |
| Punctate Nuclear | 0.0019 | 0.0042 | 0.0025 | 0.0014 | 0.0058 | 0.0033 | – | – | – | – | – | – | 0.0019 | 0.0063 | 0.004 | 0.001 | 0.0419 | 0.0086 |
| Vacuole | 0.0001 | 0 | 0 | 0 | 0.0001 | 0 | – | – | – | – | – | – | 0.0001 | 0 | 0 | 0 | 0.0001 | 0 |
| Vacuole Periphery | 0.0001 | 0 | 0 | 0 | 0.0001 | 0 | – | – | – | – | – | – | 0.0001 | 0 | 0 | 0 | 0 | 0 |
Sequencing Data
| R1 | R2 | |||||||||
|---|---|---|---|---|---|---|---|---|---|---|
| G1 Post-START | S/G2 | Metaphase | Anaphase | Telophase | G1 Post-START | S/G2 | Metaphase | Anaphase | Telophase | |
| Gene Expression | 28.5179 | 20.9665 | 28.6409 | 34.3487 | 34.7286 | 36.7598 | 30.5942 | 33.9002 | 37.895 | 37.0821 |
| Translational Efficiency | 0.6355 | 0.5678 | 0.5369 | 0.5695 | 0.5834 | 0.4993 | 0.4553 | 0.4827 | 0.4197 | 0.4756 |
Hit Data
| Dataset | Hit |
|---|---|
| Protein Concentration | – |
| Protein Localization | ✘ |
| Gene Expression | ✘ |
| Translational Efficiency | ✘ |
Micrographs
































Cell Count
| R1 | R2 | R1 & R2 | |||||||||
|---|---|---|---|---|---|---|---|---|---|---|---|
| WT | UBP2 | UBP14 | UBP2UBP14 | WT | UBP2 | UBP14 | UBP2UBP14 | WT | UBP2 | UBP14 | UBP2UBP14 |
| 1916 | 824 | 516 | 1555 | 1447 | 1669 | 189 | 872 | 3363 | 2493 | 705 | 2427 |
Protein Abundance
| R1 | R2 | R1 & R2 | ||||||||||
|---|---|---|---|---|---|---|---|---|---|---|---|---|
| WT | UBP2 | UBP14 | UBP2UBP14 | WT | UBP2 | UBP14 | UBP2UBP14 | WT | UBP2 | UBP14 | UBP2UBP14 | |
| Mean | 636.32 | 780.44 | 1087.20 | 970.41 | 717.98 | 765.99 | 1049.34 | 996.19 | 671.46 | 770.77 | 1077.05 | 979.67 |
| Standard Deviation | 85.31 | 133.04 | 158.63 | 142.21 | 116.04 | 117.15 | 126.24 | 132.18 | 107.58 | 122.82 | 151.56 | 139.24 |
| Intensity Change Log 2 | — | 0.294535 | 0.772793 | 0.608842 | — | 0.093382 | 0.547467 | 0.472477 | — | 0.191394 | 0.657729 | 0.538156 |
Localization Score (DeepLoc)
| R1 | R2 | R1 & R2 | ||||||||||
|---|---|---|---|---|---|---|---|---|---|---|---|---|
| WT | UBP2 | UBP14 | UBP2UBP14 | WT | UBP2 | UBP14 | UBP2UBP14 | WT | UBP2 | UBP14 | UBP2UBP14 | |
| Actin | 0.000339 | 0.000826 | 0.001837 | 0.001384 | 0.000356 | 0.000738 | 0.001742 | 0.001341 | 0.000346 | 0.000767 | 0.001812 | 0.001369 |
| Bud Neck | 0.003928 | 0.008241 | 0.016662 | 0.049130 | 0.004356 | 0.008643 | 0.013398 | 0.026492 | 0.004112 | 0.008510 | 0.015787 | 0.040996 |
| Bud Site | 0.002162 | 0.000843 | 0.003633 | 0.008530 | 0.000870 | 0.001984 | 0.001715 | 0.003341 | 0.001606 | 0.001607 | 0.003119 | 0.006665 |
| Cell Periphery | 0.000179 | 0.000059 | 0.000107 | 0.000169 | 0.000099 | 0.000074 | 0.000041 | 0.000065 | 0.000144 | 0.000069 | 0.000089 | 0.000132 |
| Cytoplasm | 0.057893 | 0.002457 | 0.008197 | 0.008103 | 0.004207 | 0.002487 | 0.000134 | 0.001150 | 0.034793 | 0.002478 | 0.006035 | 0.005605 |
| Cytoplasmic Foci | 0.014148 | 0.001418 | 0.000214 | 0.003805 | 0.000740 | 0.001105 | 0.000039 | 0.000957 | 0.008379 | 0.001209 | 0.000167 | 0.002782 |
| Eisosomes | 0.000051 | 0.000028 | 0.000053 | 0.000035 | 0.000025 | 0.000035 | 0.000065 | 0.000041 | 0.000039 | 0.000033 | 0.000056 | 0.000037 |
| Endoplasmic Reticulum | 0.001781 | 0.002610 | 0.005933 | 0.004883 | 0.001932 | 0.003457 | 0.004958 | 0.004286 | 0.001846 | 0.003177 | 0.005672 | 0.004669 |
| Endosome | 0.002739 | 0.000728 | 0.000348 | 0.006627 | 0.000322 | 0.000705 | 0.000166 | 0.002063 | 0.001699 | 0.000713 | 0.000299 | 0.004987 |
| Golgi | 0.003296 | 0.000932 | 0.000325 | 0.005413 | 0.000561 | 0.001241 | 0.000281 | 0.001980 | 0.002120 | 0.001139 | 0.000313 | 0.004179 |
| Lipid Particles | 0.003061 | 0.000266 | 0.000355 | 0.000456 | 0.000498 | 0.000702 | 0.000136 | 0.000161 | 0.001958 | 0.000558 | 0.000296 | 0.000350 |
| Mitochondria | 0.005093 | 0.002973 | 0.001691 | 0.007441 | 0.002109 | 0.006324 | 0.001766 | 0.005383 | 0.003809 | 0.005216 | 0.001711 | 0.006701 |
| Mitotic Spindle | 0.006543 | 0.007036 | 0.006805 | 0.056607 | 0.002675 | 0.006989 | 0.006024 | 0.015600 | 0.004879 | 0.007005 | 0.006596 | 0.041874 |
| None | 0.088207 | 0.009701 | 0.007730 | 0.005884 | 0.018888 | 0.007733 | 0.001380 | 0.002601 | 0.058381 | 0.008383 | 0.006028 | 0.004705 |
| Nuclear Periphery | 0.001257 | 0.000621 | 0.000465 | 0.003849 | 0.000491 | 0.000910 | 0.000239 | 0.004007 | 0.000927 | 0.000815 | 0.000405 | 0.003906 |
| Nuclear Periphery Foci | 0.012330 | 0.001260 | 0.000884 | 0.003854 | 0.001560 | 0.001644 | 0.000229 | 0.002004 | 0.007696 | 0.001517 | 0.000708 | 0.003189 |
| Nucleolus | 0.261621* | 0.130942 | 0.086830 | 0.039839 | 0.160032 | 0.168665 | 0.114869 | 0.067396 | 0.217910 | 0.156197 | 0.094347 | 0.049740 |
| Nucleus | 0.531348* | 0.826721* | 0.853346* | 0.764801* | 0.799093* | 0.782731* | 0.846540* | 0.848458* | 0.646551* | 0.797271* | 0.851522* | 0.794858* |
| Peroxisomes | 0.001893 | 0.000863 | 0.001290 | 0.000774 | 0.000669 | 0.001363 | 0.002049 | 0.000847 | 0.001367 | 0.001198 | 0.001494 | 0.000800 |
| Vacuole | 0.001497 | 0.000704 | 0.003015 | 0.017480 | 0.000293 | 0.001363 | 0.003725 | 0.006582 | 0.000979 | 0.001145 | 0.003205 | 0.013564 |
| Vacuole Periphery | 0.000636 | 0.000769 | 0.000280 | 0.010935 | 0.000225 | 0.001104 | 0.000503 | 0.005246 | 0.000459 | 0.000994 | 0.000340 | 0.008891 |
Localization Changes (T-score)
| R1 | R2 | R1 & R2 | |||||||||||||
|---|---|---|---|---|---|---|---|---|---|---|---|---|---|---|---|
| UBP2_WT | UBP14_WT | UBP2UBP14_WT | UBP2UBP14_UBP2 | UBP2UBP14_UBP14 | UBP2_WT | UBP14_WT | UBP2UBP14_WT | UBP2UBP14_UBP2 | UBP2UBP14_UBP14 | UBP2_WT | UBP14_WT | UBP2UBP14_WT | UBP2UBP14_UBP2 | UBP2UBP14_UBP14 | |
| Actin | -5.51 | -13.61 | -17.04 | -8.14 | 3.74 | -5.96 | -11.38 | -17.50 | -11.17 | 1.96 | -8.06 | -16.75 | -23.37 | -13.82 | 4.25 |
| Bud Neck | -6.01 | -12.00 | -24.18 | -20.86 | -9.81 | -5.85 | -4.90 | -14.54 | -12.14 | -5.85 | -8.24 | -12.83 | -28.05 | -23.99 | -10.88 |
| Bud Site | 5.17 | -4.49 | -7.65 | -10.47 | -1.78 | -1.88 | -3.63 | -6.05 | -3.64 | -2.57 | 0.29 | -5.66 | -9.79 | -8.77 | -2.10 |
| Cell Periphery | 9.49 | 4.79 | 2.94 | -5.23 | -1.31 | 1.43 | 2.70 | 1.26 | -0.38 | -2.89 | 6.91 | 4.18 | 2.64 | -4.38 | -1.52 |
| Cytoplasm | 18.24 | 16.41 | 16.94 | -3.30 | -0.78 | 2.07 | 5.55 | 3.29 | 1.47 | -4.15 | 17.75 | 15.51 | 16.42 | -2.88 | -0.79 |
| Cytoplasmic Foci | 9.60 | 11.57 | 10.51 | 0.14 | -3.11 | -0.35 | 3.37 | 1.49 | 1.68 | -1.68 | 9.84 | 11.73 | 10.35 | 0.50 | -3.43 |
| Eisosomes | 5.33 | -0.72 | 2.56 | -6.80 | 5.23 | -4.71 | -10.05 | -11.65 | -6.68 | 4.46 | 3.15 | -5.47 | -1.06 | -8.10 | 6.47 |
| Endoplasmic Reticulum | -4.36 | -8.89 | -14.17 | -9.39 | 0.52 | -5.72 | -8.41 | -8.42 | -3.54 | 1.08 | -7.45 | -10.81 | -16.37 | -8.67 | 1.07 |
| Endosome | 6.05 | 7.81 | 0.91 | -3.85 | -4.71 | -1.95 | 1.52 | -1.91 | -1.07 | -2.28 | 5.58 | 7.64 | -0.37 | -4.14 | -5.14 |
| Golgi | 5.29 | 8.16 | 2.89 | -1.75 | -3.01 | -1.40 | 1.45 | -0.85 | 0.31 | -1.37 | 3.46 | 8.07 | 1.85 | -1.16 | -3.25 |
| Lipid Particles | 8.20 | 7.80 | 8.09 | -0.59 | 1.28 | -0.43 | 1.97 | 2.01 | 1.83 | 0.14 | 5.47 | 7.73 | 8.18 | 1.46 | 1.59 |
| Mitochondria | 2.11 | 7.53 | -1.08 | -2.60 | -7.27 | -3.95 | 0.06 | -2.20 | 1.28 | -2.32 | -1.66 | 4.87 | -2.70 | -0.32 | -6.59 |
| Mitotic Spindle | 1.04 | -2.10 | -8.18 | -8.13 | -4.47 | -2.19 | -0.90 | -4.90 | -3.77 | -2.37 | -0.04 | -2.67 | -9.74 | -9.39 | -4.71 |
| None | 19.74* | 21.57 | 22.49 | 2.69 | 0.54 | 4.78 | 8.24 | 7.52 | 4.89 | -4.55 | 20.05 | 21.67 | 22.79 | 4.60 | 0.33 |
| Nuclear Periphery | 2.56 | 0.99 | -7.28 | -9.53 | -8.13 | -3.11 | 0.90 | -2.68 | -2.17 | -2.83 | 0.46 | 0.56 | -6.74 | -7.10 | -6.93 |
| Nuclear Periphery Foci | 9.62 | 8.97 | 9.21 | -0.98 | 0.28 | 0.16 | 3.39 | 1.16 | 1.21 | -1.99 | 9.20 | 8.87 | 9.03 | 0.04 | -0.09 |
| Nucleolus | 18.74* | 16.15 | 36.72* | 15.72 | 10.40 | -1.40 | 3.34 | 13.73 | 15.93 | 4.13 | 13.57* | 14.09 | 37.62* | 25.94 | 10.64 |
| Nucleus | -33.64* | -24.63 | -31.39 | 2.80 | -0.72 | 2.01 | -2.43 | -3.77 | -5.62 | -0.05 | -24.97 | -18.52 | -25.41 | -2.34 | -1.01 |
| Peroxisomes | 6.02 | 3.15 | 7.82 | 2.65 | 6.29 | -2.28 | -5.04 | -0.80 | 2.06 | 5.13 | 2.66 | 0.06 | 6.95 | 3.30 | 7.81 |
| Vacuole | 3.18 | -4.73 | -7.23 | -7.80 | -4.72 | -2.65 | -1.69 | -4.42 | -3.26 | -0.15 | -0.41 | -4.30 | -8.47 | -8.09 | -3.74 |
| Vacuole Periphery | -0.70 | 4.31 | -3.94 | -3.66 | -4.24 | -3.30 | -1.10 | -2.19 | -1.30 | -1.78 | -2.82 | 0.38 | -4.54 | -3.59 | -4.56 |
Endocytosis
| Temp | Actin Patch (Sac6-tdTomato) | Cortical Patch (Sla1-GFP) | Late Endosome (Snf7-GFP) | Vacuole (Vph1-GFP) |
|---|---|---|---|---|
| 37℃ | ||||
| RT |
Cell Cycle Omics
CYCLoPs (Yta7-GFP)
| Gene / Allele | Actin Patch (Sac6-tdTomato) | Cortical Patch (Sla1-GFP) | Late Endosome (Snf7-GFP) | Vacuole (Sac6-tdTomato) |
|---|
| Gene | Images |
|---|
| Gene | Images |
|---|
Images are not yet available
Images are not yet available